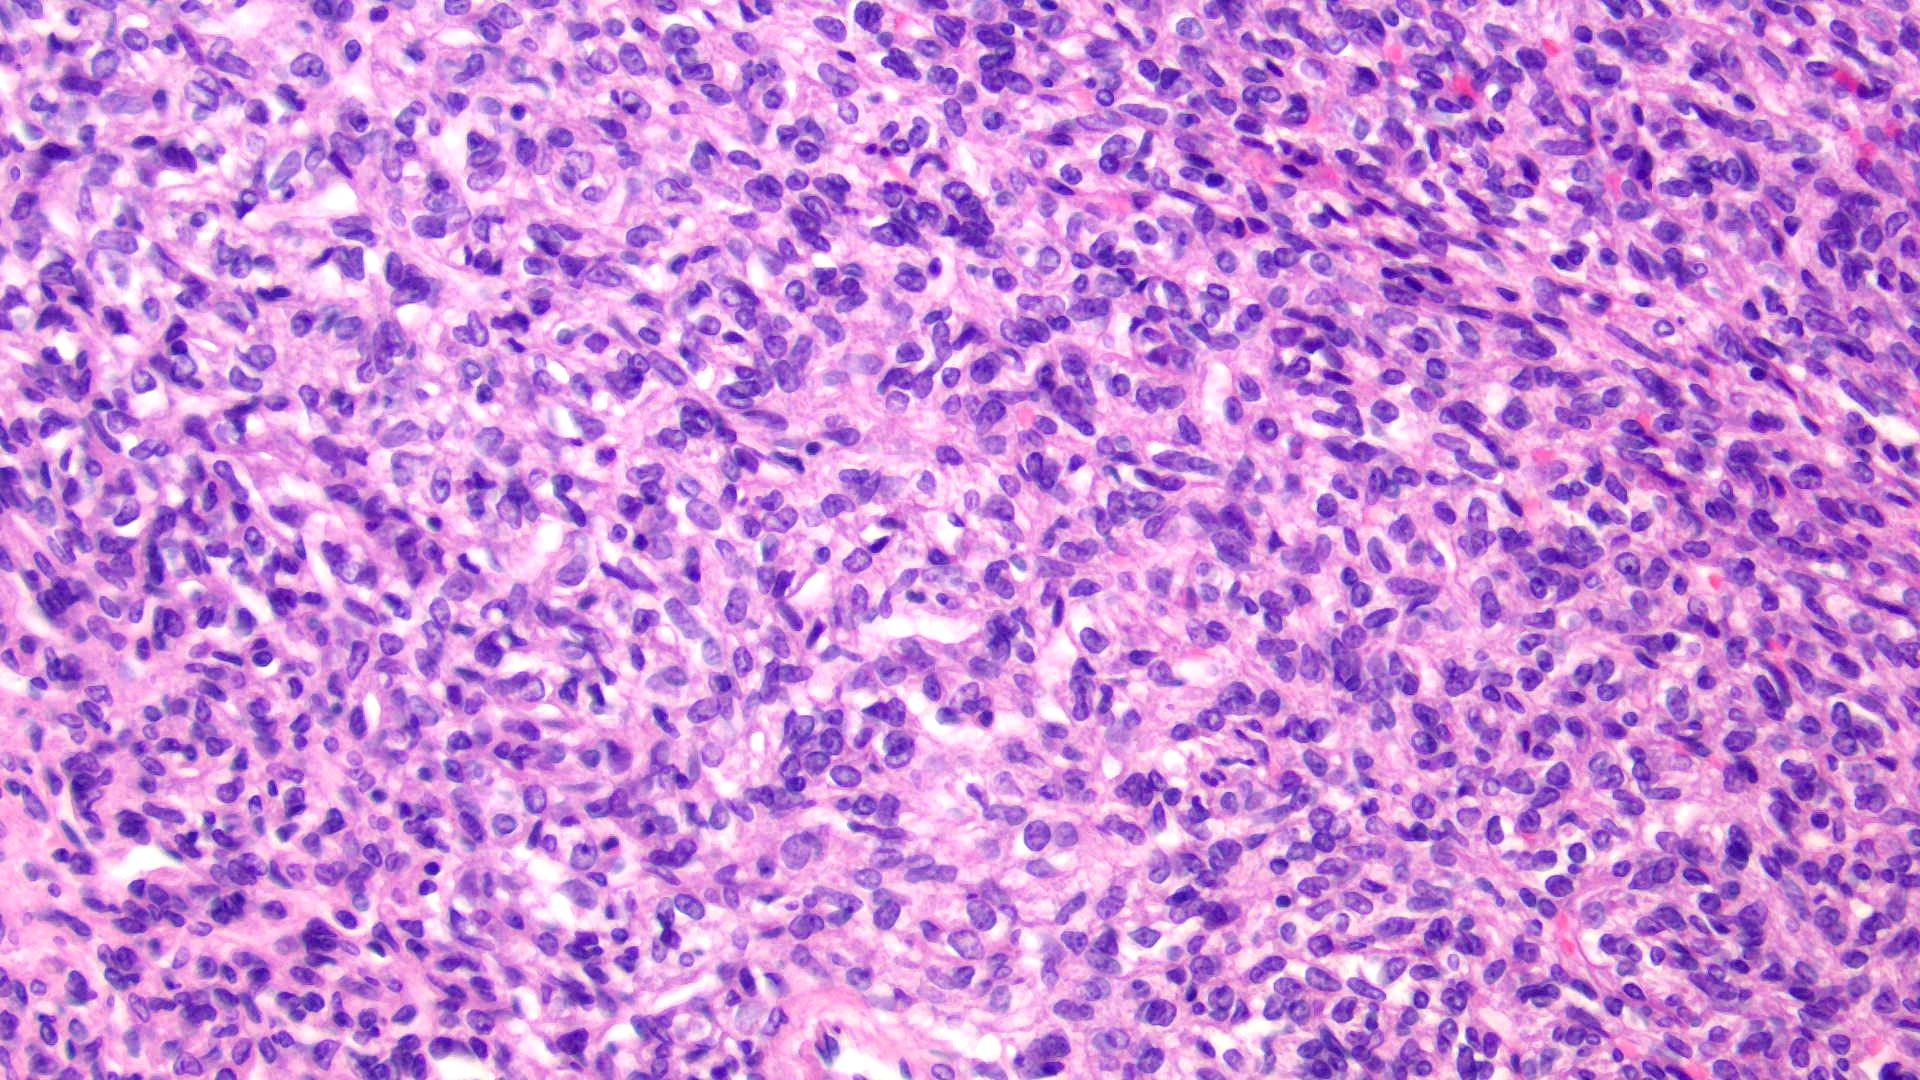
WIN 20201023 14 54 18 Pro

Case History
Patient history:
42-year-old male with hypoglycemia, altered mental status, and large skull-based mass with prominent veins. Diagnosis and genetics? (H&E and CD34)
What is the diagnosis?
A. Hemangioblastoma / Chromosome 3
B. Hemangiopericytoma / NAB2-STAT6 fusion
C. Hemangioma / GLUT1
D. Kaposi sarcoma / HHV8

Answer: B: Hemangiopericytoma / NAB2-STAT6 fusion

Case contributed by: Astin Powers, MD, Fellow, Neuropathology